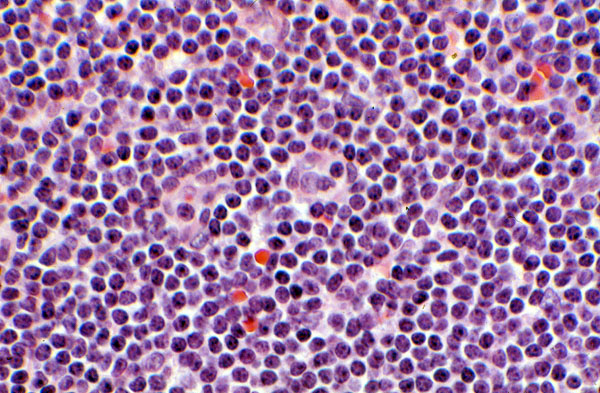

Small lymphocytic lymphoma, lymph node, histology
Click picture to enlarge. Close window to return
This lymphoma shows a diffuse growth pattern and is composed of a monotonous population of small, mature lymphocytes which are histologically indistinguishable from the cells of CLL.